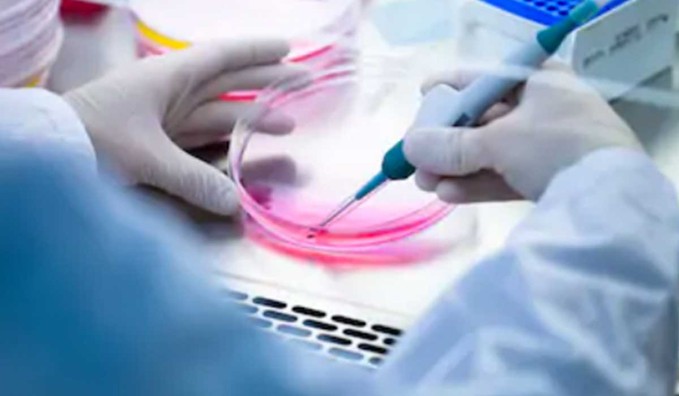

| Catalog # | Product Name | Description |
|
B1010
|
Bovine Adrenal Microvascular Endothelial Cells
|
Bovine Adrenal Microvascular Endothelial
Cells- 1ml frozen Vial- liquid Nitrogen Vapor Phase -80°C Product Data
Sheet
|
|
B1011
|
Bovine Aortic Endothelial Cells
|
Bovine Aortic Endothelial Cells- 1ml frozen
Vial- liquid Nitrogen Vapor Phase -80°C Product Data Sheet
|
|
B1012
|
Bovine Brain Microvascular Endothelial Cells
|
Bovine Brain Microvascular Endothelial Cells-
1ml frozen Vial- liquid Nitrogen Vapor Phase -80°C Product Data Sheet
|
|
B1013
|
Bovine Cardiac Microvascular Endothelial Cells
|
Bovine Cardiac Microvascular Endothelial
Cells- 1ml frozen Vial- liquid Nitrogen Vapor Phase -80°C Product Data
Sheet
|
|
B1014
|
Bovine Coronary Artery Endothelial Cells
|
Bovine Coronary Artery Endothelial Cells- 1ml
frozen Vial- liquid Nitrogen Vapor Phase -80°C Product Data Sheet
|
|
B1015
|
Bovine Glomerular Microvascular Endothelial
Cells
|
Bovine Glomerular Microvascular Endothelial
Cells- 1ml frozen Vial- liquid Nitrogen Vapor Phase -80°C Product Data
Sheet
|
|
B1016
|
Bovine Lung Microvascular Endothelial Cells
|
Bovine Lung Microvascular Endothelial Cells-
1ml frozen Vial- liquid Nitrogen Vapor Phase -80°C Product Data Sheet
|
|
B1017
|
Bovine Pulmonary Artery Endothelial Cells
|
Bovine Pulmonary Artery Endothelial Cells- 1ml
frozen Vial- liquid Nitrogen Vapor Phase -80°C Product Data Sheet
|
|
B1018
|
Bovine Renal Artery Endothelial Cells
|
Bovine Renal Artery Endothelial Cells- 1ml
frozen Vial- liquid Nitrogen Vapor Phase -80°C Product Data Sheet
|
|
B1019
|
Bovine Retinal Microvascular Endothelial Cells
|
Bovine Retinal Microvascular Endothelial
Cells- 1ml frozen Vial- liquid Nitrogen Vapor Phase -80°C Product Data
Sheet
|
|
B1020
|
Bovine Skeletal Muscle Microvascular
Endothelial Cells
|
Bovine Skeletal Muscle Microvascular
Endothelial Cells- 1ml frozen Vial- liquid Nitrogen Vapor Phase
-80°C Product Data Sheet
|
|
B1021
|
GFP Expressing Bovine Aortic Endothelial Cells
|
GFP Expressing Bovine Aortic Endothelial
Cells- 1ml frozen Vial- liquid Nitrogen Vapor Phase -80°C
|
|
M1010
|
Mouse Aortic Endothelial Cells
|
Mouse Aortic Endothelial Cells- 1ml frozen
Vial- liquid Nitrogen Vapor Phase -80°C
|
|
M1011
|
Mouse Brain Microvascular Endothelial Cells
|
Mouse Brain Microvascular Endothelial Cells-
1ml frozen Vial- liquid Nitrogen Vapor Phase -80°C
|
|
P1022
|
Porcine Aortic Endothelial Cells
|
Porcine Aortic Endothelial Cells- 1ml frozen
Vial- liquid Nitrogen Vapor Phase -80°C
|
|
P1023
|
Porcine Coronary Artery Endothelial Cells
|
Porcine Coronary Artery Endothelial Cells- 1ml
frozen Vial- liquid Nitrogen Vapor Phase -80°C
|
|
P1024
|
RFP Expressing Porcine Aortic SMACs
|
RFP Expressing Porcine Aortic SMACs- 1ml
frozen Vial- liquid Nitrogen Vapor Phase -80°C
|
|
R1015
|
Rat Neonatal Cardiac Fibroblasts
|
Rat Neonatal Cardiac Fibroblasts- 1ml frozen
Vial- liquid Nitrogen Vapor Phase -80°C Product Data Sheet
|
|
R1016
|
Rat Neonatal Dermal Fibroblasts
|
Rat Neonatal Dermal Fibroblasts- 1ml frozen
Vial- liquid Nitrogen Vapor Phase -80°C Product Data Sheet
|
|
R1017
|
Rat Neonatal Lung Fibroblasts
|
Rat Neonatal Lung Fibroblasts- 1ml frozen
Vial- liquid Nitrogen Vapor Phase -80°C Product Data Sheet
|
